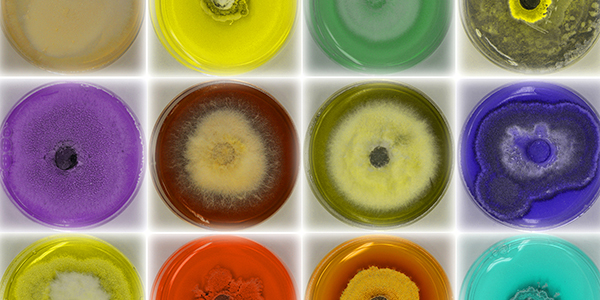
An image of different species of fungi that can be used as a healing agent in sustainable structures.

Art of Science contest returns for 2019
Advances in imaging technology and tools mean that scientists have an increased ability to generate exciting data as well as to create compelling works of art.

Advances in imaging technology and tools mean that scientists have an increased ability to generate exciting data as well as to create compelling works of art. Binghamton University’s third-annual Art of Science contest offers an opportunity to share the beauty of science through photographs and images that describe some aspect of research captured visually.
Binghamton students, postdocs, faculty and staff members will compete in the following categories:
- The World Around Us: images in which the subject is visible to the naked eye
- Visualizing the Unseen: images captured with the use of optics that extend beyond what the eye can see, such as microscopes and telescopes
- Imagining Science: images that depict objects too small to be visualized directly, models of scientific phenomena or processes or interpretations of scientific information
Images will be evaluated based on scientific significance, originality and artistic and visual impact. This year’s judges are: Hiroki Sayama, director of the Center for Collective Dynamics of Complex Systems and professor in the Department of Systems Science and Industrial Engineering; John Tagg, SUNY distinguished professor of art history; Anju Sharma, senior scientist in the Analytical and Diagnostics Laboratory; undergraduate Rebecca Kiss, photo editor of Pipe Dream; alumnus and professional photographer Wasim Ahmad; and Joshua B. Ludzki, alumnus and co-founder of the LUMA Projection Arts Festival.
Entries are due by Feb. 22, 2019. For further details, visit http://go.binghamton.edu/artofscience.